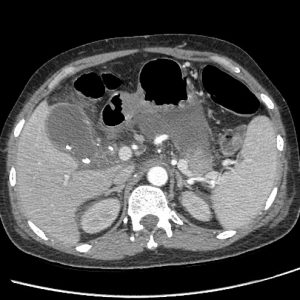
Viêm tụy

TIÊU HOÁ
Hiển thị 261–280 của 1445 kết quảĐã sắp xếp theo mới nhất
-

Chấn thương lách
Lượt xem: 154» 24-11-2020 -

Chấn thương lách
Lượt xem: 156» 24-11-2020 -

Chấn thương lách
Lượt xem: 141» 24-11-2020 -

Chấn thương lách
Lượt xem: 171» 24-11-2020 -

Chấn thương lách
Lượt xem: 179» 23-11-2020 -

Chấn thương lách
Lượt xem: 94» 23-11-2020 -

chấn thương lách
Lượt xem: 150» 23-11-2020 -

Chấn thương lách
Lượt xem: 162» 23-11-2020 -

Chấn thương lách
Lượt xem: 152» 23-11-2020 -

Chấn thương lách
Lượt xem: 178» 23-11-2020 -

Chấn thương lách
Lượt xem: 169» 23-11-2020 -

Chấn thương lách
Lượt xem: 160» 23-11-2020 -

Chấn thương lách
Lượt xem: 204» 23-11-2020 -

Chấn thương lách
Lượt xem: 198» 23-11-2020 -

Chấn thương lách
Lượt xem: 161» 23-11-2020 -

Viêm tụy
Lượt xem: 214» 23-11-2020 -

Sán lá gan
Lượt xem: 221» 23-11-2020 -

U tuyến thượng thận
Lượt xem: 199» 23-11-2020 -

U dạ dày
Lượt xem: 159» 23-11-2020 -

U tụy
Lượt xem: 229» 23-11-2020